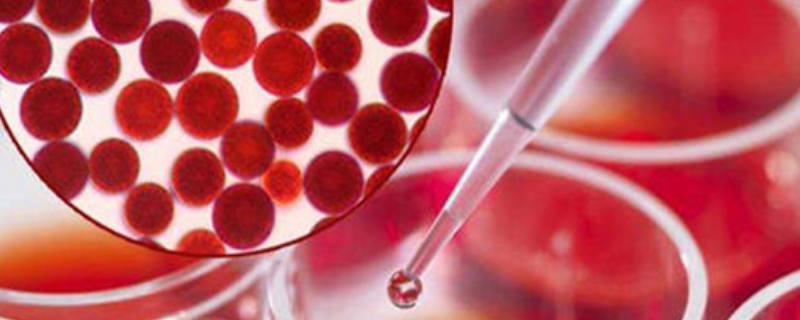

虾青素是红色才是正常的。虾青素又名虾黄素、龙虾壳色素、变胞藻黄素等。1938年,德国化学家理查德-库恩从龙虾体内提取了一种色素,并发现它是一种较强的天然抗氧化剂,这就是虾青素。由于最早是在虾体内发现的,在活体虾中虾青素与蛋白质结合在一起,呈现出蓝色,故命名为虾青素。与蛋白质结合的虾青素在加工过程中,由于加热使蛋白质变性,会释放出虾青素而恢复原有的红色。
虾青素是红色才是正常的。虾青素又名虾黄素、龙虾壳色素、变胞藻黄素等。1938年,德国化学家理查德-库恩从龙虾体内提取了一种色素,并发现它是一种较强的天然抗氧化剂,这就是虾青素。由于最早是在虾体内发现的,在活体虾中虾青素与蛋白质结合在一起,呈现出蓝色,故命名为虾青素。与蛋白质结合的虾青素在加工过程中,由于加热使蛋白质变性,会释放出虾青素而恢复原有的红色。